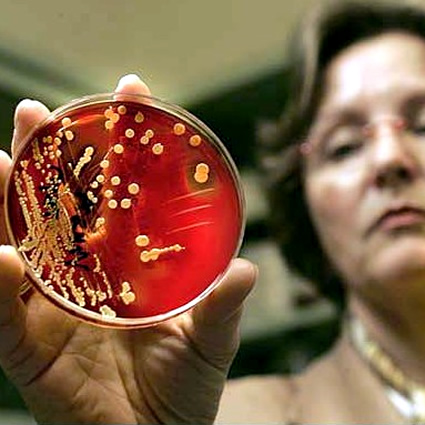

Dal 24 al 30 aprile si celebra la Settimana Mondiale dei Vaccini e MSD, uno leader globali nella lotta alle malattie prevenibili attraverso la vaccinazione, lancia un importante grido di allarme.

Dal 24 al 30 aprile si celebra la Settimana Mondiale dei Vaccini e MSD, uno leader globali nella lotta alle malattie prevenibili attraverso la vaccinazione, lancia un importante grido di allarme.

Dal 24 al 30 aprile viene celebrata la Settimana mondiale delle vaccinazioni e la SIN, Società Italiana di Neonatologia, ha deciso di affidare direttamente ai neonatologi iscritti alla Società scientifica la campagna di comunicazione. Nel massimo rispetto della libertà individuale dei medici e delle scelte dei genitori, ogni neonatologo iscritto alla SIN si impegnerà personalmente ad informare i genitori sui rischi derivanti dalla mancata vaccinazione.